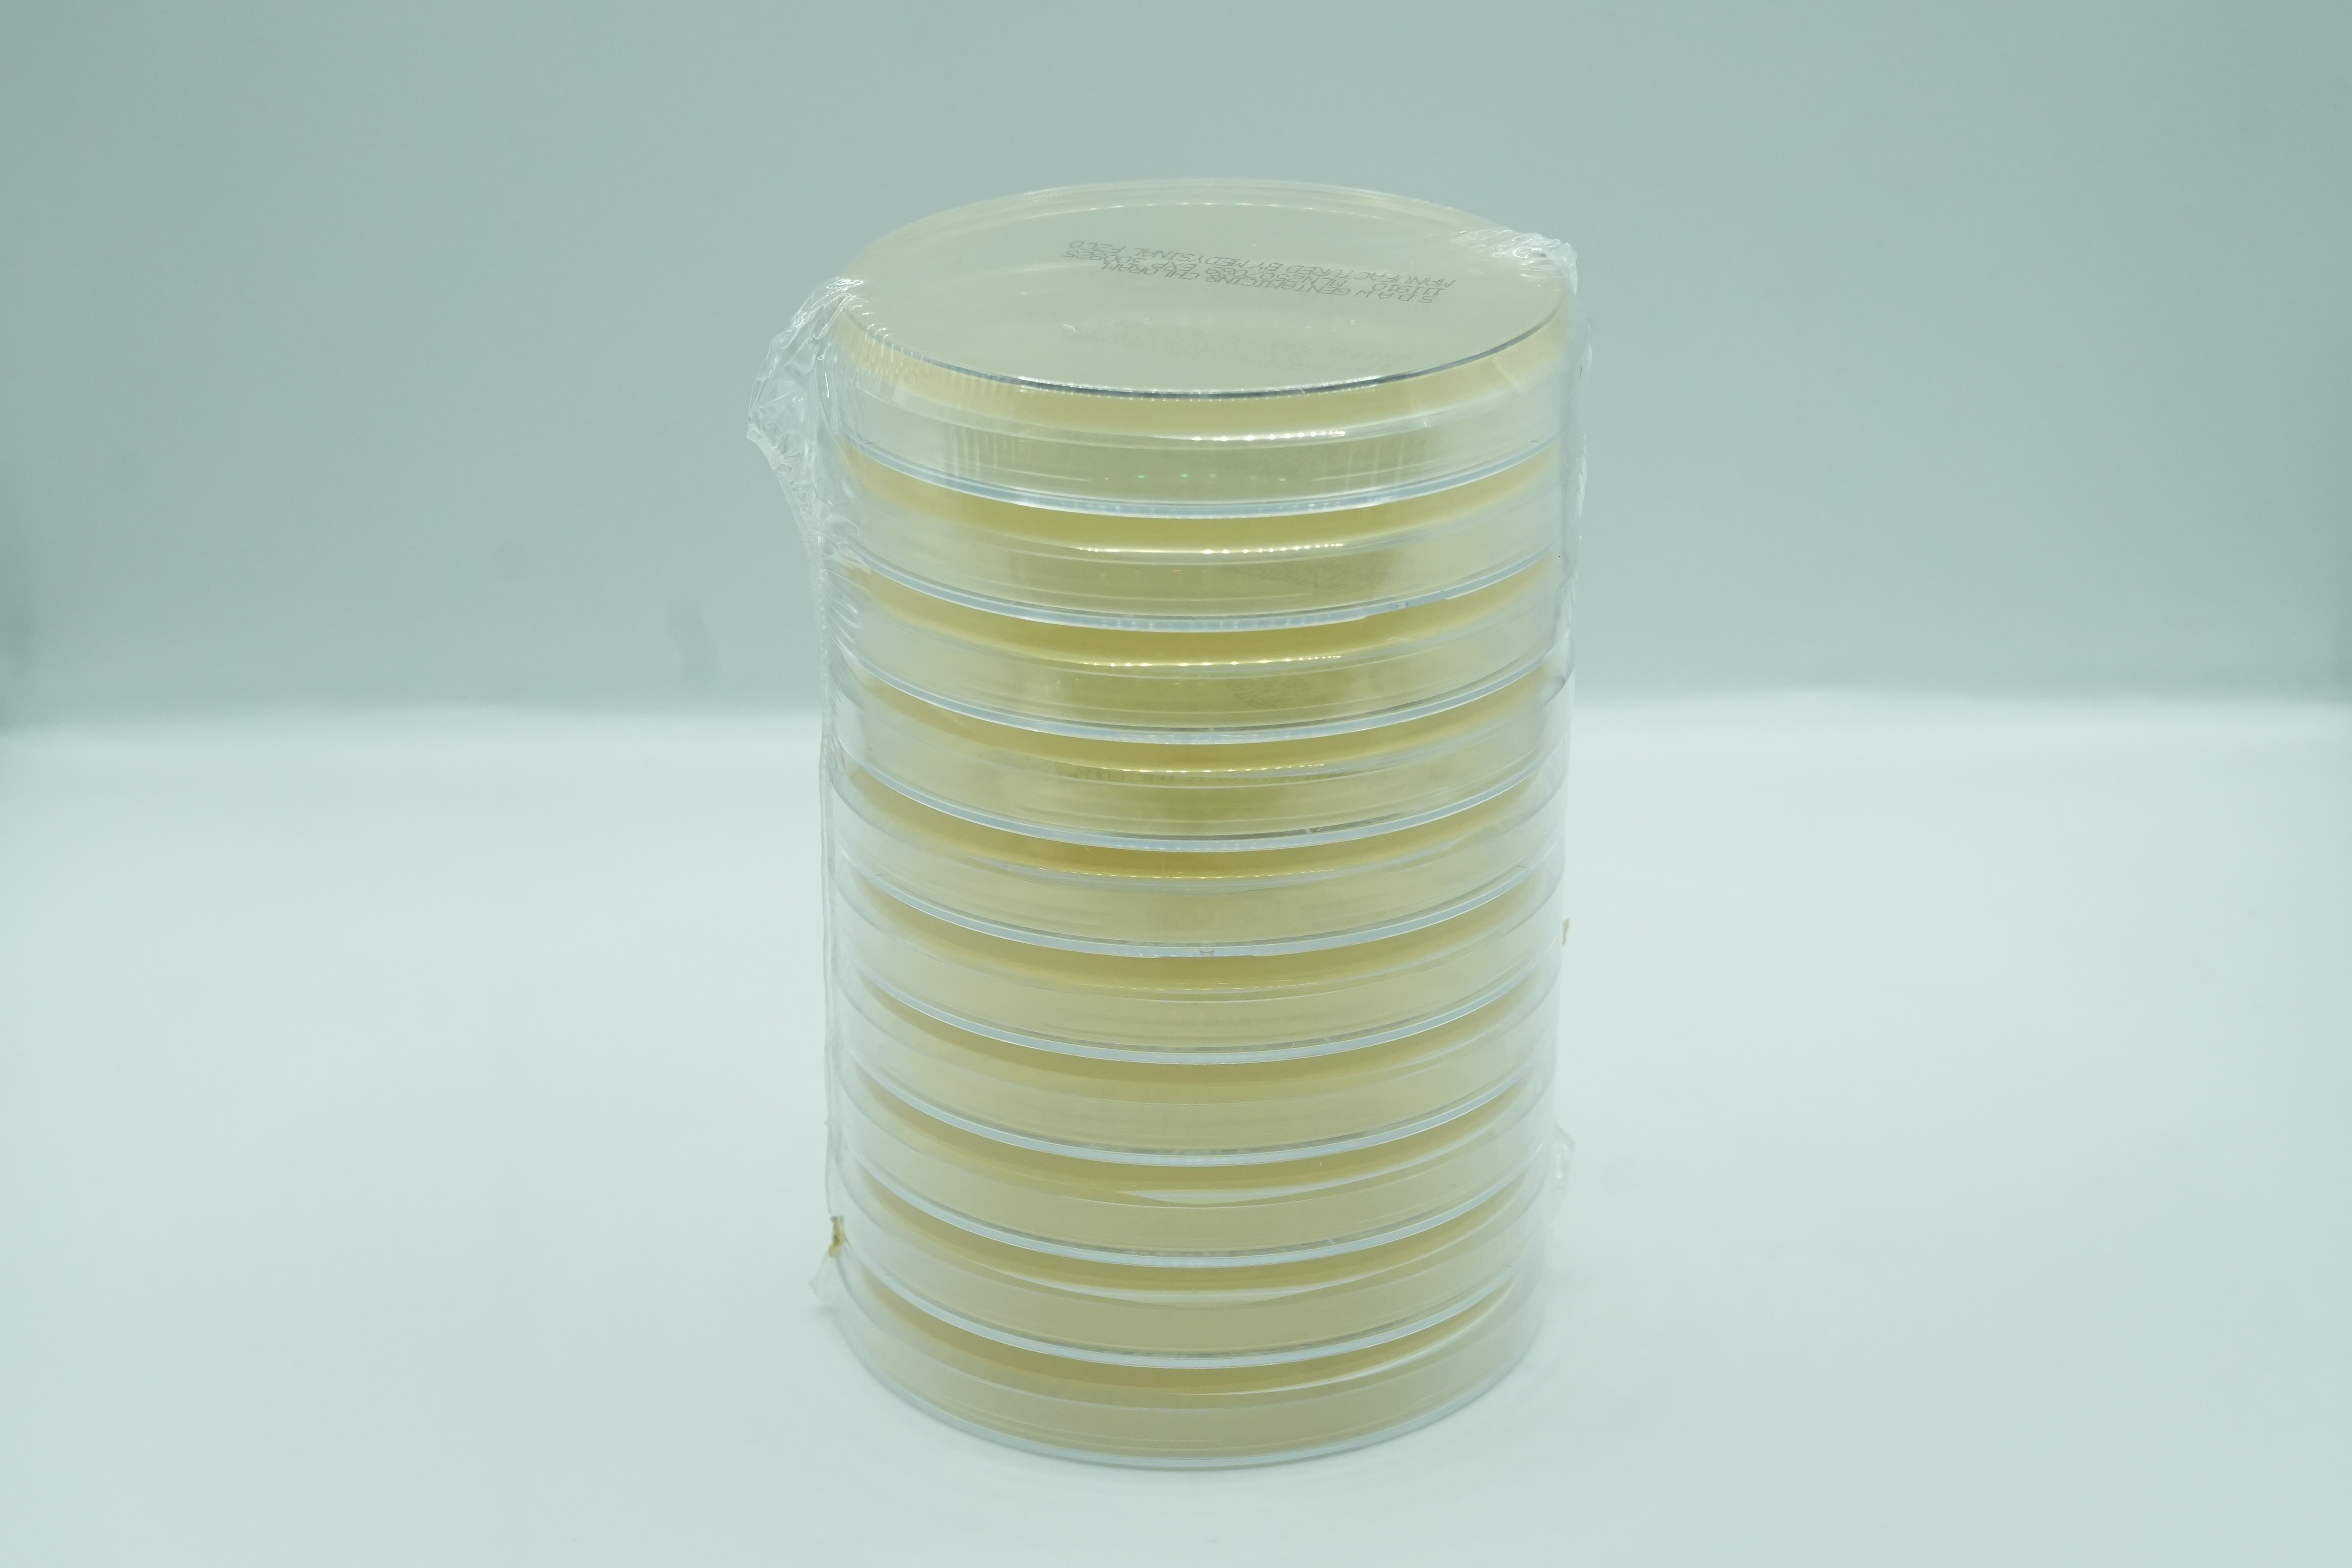

Thank you for your interest We will reach out to you

Oops! Something went wrong while submitting the form.
.svg)
Find a Product
Thank you! Your submission has been received!
Oops! Something went wrong while submitting the form.

Slanetz and Bartley Agar (S&B) 60MM
113006

Legionella GVPC Selective Agar 60MM
113004

Bordetella Gengou Agar
110206

Methylene Blue-ZN Acid Fast Stain
1010
%20Agar%201.png)
BCYE (Buffered Charcoal Yeast Extract) Agar
110213

Mueller Hinton Blood Agar
111306

Selectrol® Escherichia coli O157 non-toxigenic NCTC® 12900 / ATCC® 700728

Sab. Dex Agar with Chloremphenicol
111909

Selectrol® Pseudomonas paraeruginosa NCTC® 12924 / ATCC® 9027

Columbia CNA Blood Agar
110306

CDC Blood Agar / Schaedler KV Blood Agar
120205

Selectrol® Klebsiella pneumoniae (CRE) NCTC® 13440

Phenylethyl Alcohol Agar w 5% Sheep Blood
111616

TSB w/ 15% Glycerol
4397809

Medygraine 50Mg
110102

Brucella Modified Blood Agar
110222

Yeast glucose chloramphenicol agar 90MM
110239

Blood/MacConkey Agar Biplate
120401

Selectrol® Streptococcus pneumoniae NCTC® 12695 /ATCC® 6303

Brucella Blood Agar w Hemin & Vit K1
110209

CHROMagar StrepB Agar
110333

Sabouraud Dextrose Agar w Gentamycin
111907

Selectrol® Klebsiella pneumoniae NCTC® 9633 / ATCC® 13883

Selectrol® Listeria monocytogenes NCTC® 10527 / ATCC® 13932

Sheep Blood Agar/Sheep Blood Agar Biplate
120411

Bile Esculin Azide Agar
110221

Potassium Permanganate - TB fluoroscent Kit
1016

Selectrol® Pseudomonas aeruginosa NCTC® 13359 / ATCC® 15442

Selectrol® Listeria monocytogenes NCTC® 11994

Sterile Water 5ml
412003

SABHI Agar Slants
4321014

Trypticase Soy Broth
4321715

Selectrol® Proteus vulgaris NCTC® 4175 / ATCC® 13315

Selectrol® Escherichia coli NCTC® 11954 / ATCC® 35218

RPMI
111803

Selectrol® Listeria innocua NCTC® 11288 / ATCC® 33090

Cetrimide Agar 60mm
113001

Selectrol® Haemophilus influenzae NCTC® 8468 / ATCC® 9334

Violet Red Bile Agar (Ready-made plates)
111202

Selectrol® Streptococcus pyogenes NCTC® 12696 /ATCC® 19615

Selectrol® Yersinia enterocolitica NCTC® 12982 / ATCC® 9610

Gram's safranin O
1004

Medygraine 100Mg
110103

MEDYFAST-RT STREP A Kit 20 tests
511503

MEndo LES Agar 60MM
113005

Selectrol® Staphylococcus epidermidis NCTC® 13360 / ATCC® 12228

BHI Agar w Vancomycin
110214

Selectrol® Clostridium perfringens NCTC® 8237 / ATCC® 13124

MEDYFAST-RT Influenza A+B Kit 20 tests
511501

Selectrol® Neisseria gonorrhoeae NCTC® 12700 / ATCC® 49226

Sheep Blood Agar / Mueller Hinton Agar
120404

Eosin Methylene Blue (EMB) Agar
110501

Sheep Blood Agar
111904

CHROMagar VRE
110326

Chromogenic Candida
110314

Legionella with PNV Agar
110808

Selectrol® Legionella anisa NCTC® 11974 / ATCC® 35292

Selectrol® Candidozyma auris NCPF® 8977 (formerly Candida auris)

CHROMagar Y.enterocolitica
110332

Blood/MacConkey without CV Agar Biplate
120402

DNASE Test Agar w Toluidine
110404

Selectrol® Salmonella Enteritidis NCTC ® 12694 / ATCC® 13076

10% Barium Chloride
1006

Selectrol® Escherichia coli NCTC® 12923 / ATCC® 8739

SABHI Agar w Gentamicin & Chloramphenicol
111918

Selectrol® Pseudomonas aeruginosa NCTC® 12903 / ATCC® 27853

Pseudomonas Cepacia Medium
111611

Selectrol® Enterococcus faecalis NCTC® 775 / ATCC® 19433

Selectrol® Bacillus subtilis subsp spizizenii NCTC® 10400 / ATCC® 6633

Soy Agar W/ Lecithin and Polysorbate 80 150mm
212006

Salmonella Shigella Agar
111902
%20(4).png)
Violet Red Bile(VRB) Agar
322202

Pseudosel Agar
351603

Thiosul. Citrate Bile Salts Sucr. (TCBS) Agar
112001
%201.png)
Mueller Hinton Broth (5 ml)
4397220

Selectrol® Staphylococcus aureus NCTC® 12981 / ATCC® 25923

Simmons Citrate Slants
4321026

Trypticase Soy Agar with Beta Lactamase
112009

Bascillus Cereus Agar 90MM
110205

Sab Dex w Gentamicin& Chloramphenicol
111910

Selectrol® Raoultella planticola NCTC® 9528 formerly Klebsiella aerogenes

Selectrol® Proteus mirabilis NCTC® 10975

Lysine Iron Slant 10 Tubes
4320952

Selectrol® Candida albicans NCPF® 3179 / ATCC® 10231

Campylobactor BLD-Free Sel. Medium
110316

GBS Agar
110702

Selectrol® Staphylococcus aureus NCTC® 12981 / ATCC® 25923

Columbia Laked Horse Blood Agar
110317

Salt Broth 6.5%
419001

Diabetica Travel Bag
110203

Oxytetracycline Glucose Yeast Agar 90MM
110237

Carbolfuchsin Stain-ZN Acid Fast Stain
1008

Selectrol® Staphylococcus aureus NCTC® 12973 / ATCC® 29213

Selectrol® Klebsiella pneumoniae (CRE) NCTC® 13442

Selectrol® Candida albicans NCPF® 3179 / ATCC® 10231

Cled Agar
110305

Loweinstein-Jensen (LJ) Slants
4321387

Alkaline Peptone Water
4397814

Endo Agar
110502

MFC (M Fecal Coliform) Agar 60MM
113007
.svg)

.svg)

.svg)